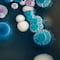

Murió Javier Acosta, el hincha de Millonarios que pidió la eutanasia y ardió Colombia en solidaridad por su dolor.
Originario de Bogotá, el hombre de 36 años de edad quedó en silla de ruedas desde hace 9 años tras un accidente automovilístico. Sin embargo, en el 2019 contrajo una bacteria en una piscina que desencadenó en cáncer de sangre (leucemia).
Después de 5 años luchando con su enfermedad, Javier Acosta pidió la eutanasia y murió el viernes 30 de agosto de 2024 en el Hospital Universitario San Ignacio de Bogotá.

El procedimiento al hincha de Millonarios, hizo arder Colombia, México y al resto de Latinoamérica con su historia-, tuvo lugar de forma privada y a petición de su familia.
Javier Acosta murió tras solicitar la eutanasia en Colombia; este fue su último mensaje
El aficionado de Millonarios, Javier Acosta, murió el 30 de agosto de 2024, luego de someterse a la eutanasia en el Hospital Universitario San Ignacio.

El viernes 30 de agosto de 2024 se sometió a este procedimiento, que se realizó de manera privada por petición de su familia. La eutanasia es la intervención deliberada para poner fin a una vida sin perspectiva de cura.
En el Hospital Universitario San Ignacio le hicieron un pasillo con aplausos a Javier Acosta antes de realizarse la eutanasia.
Posteriormente el Hospital Universitario San Ignacio de Bogotá, Colombia, informó que se realizó el egreso del paciente Javier Acosta. “Acompañamos a cada uno de los familiares, amigos y conocidos de Javier, que han estado de manera constante durante todo este proceso”, escribió en un comunicado.
Javier Acosta se mantuvo muy activo en su cuenta de Facebook hasta el 28 de agosto, fecha en el que publicó su último mensaje. Este fue de agradecimiento para quienes se conmovieron con su historia de vida y, en particular, para una persona que le dibujó.
“Gracias por plasmar mi rostro en ese papel así como yo dejo plasmada mi vida y mi lucha en cada uno de sus corazones. Gracias totales” escribió Javier Acosta como último mensaje antes de someterse a la eutanasia.


Javier Acosta se sometió a la eutanasia en Colombia
El hincha del equipo bogotano de fútbol Millonarios, informó en una transmisión en vivo que se someterá a la eutanasia.
Esto tras vivir 5 años con un hongo llamado Candida auris, misma que se extendió a sus huesos y finalmente le provocó cáncer en la sangre.
Cabe destacar que el hincha de Millonarios se encuentra en silla de ruedas desde hace 9 años, cuando fue víctima de un accidente automovilístico cuando viajó a ver a su equipo Millonarios a la ciudad de Tuluá.
Sufrí un accidente por temas de fútbol. Viajé a ver a mi equipo Millonarios a la ciudad de Tuluá y en el trayecto de regreso tuve un accidente de tránsito en el que lastimosamente quedé en silla de ruedas y llevo 9 años con el trauma raquimedular. Ese fue el accidente por el cual quedé en silla de ruedas.
Javier Acosta
Javier Acosta señaló que la cita para su eutanasia está programada para este viernes 30 de agosto a las 12:00 horas, con la cual “se va de este mundo despidiéndose de todos”.
De igual manera, el hincha de Millonarios indicó que “se lleva” el dolor de su mamá, su hermana, su hija y de su familia, pero que lo hace tranquilo pues sus seres queridos lo apoyan a pesar de que no es una decisión fácil.
Ardió Colombia por la historia de Javier Acosta, hincha de Millonarios
Todo Colombia ardió al conocer la historia de Javier Acosta, ya que en redes sociales comenzaron a manifestar su solidaridad con el hincha de Millonarios.
Muchos señalan que no es una decisión fácil someterse a la eutanasia, por lo que resaltan el valor que esto supone e indican que “nadie sabe el dolor por el que atraviesa”.
Sin embargo, Javier Acosta no se va de este mundo sin un regalo especial de los Millonarios. Esto porque el delantero del equipo de fútbol, Falcao García, junto con su esposa Loreléi Tarón, realizaron una llamada con el hincha donde rezaron por él.
Asimismo, el futbolista le prometió a Javier Acosta que le dedicará su primer gol con el equipo Millonarios aunque ya no pueda verlo.